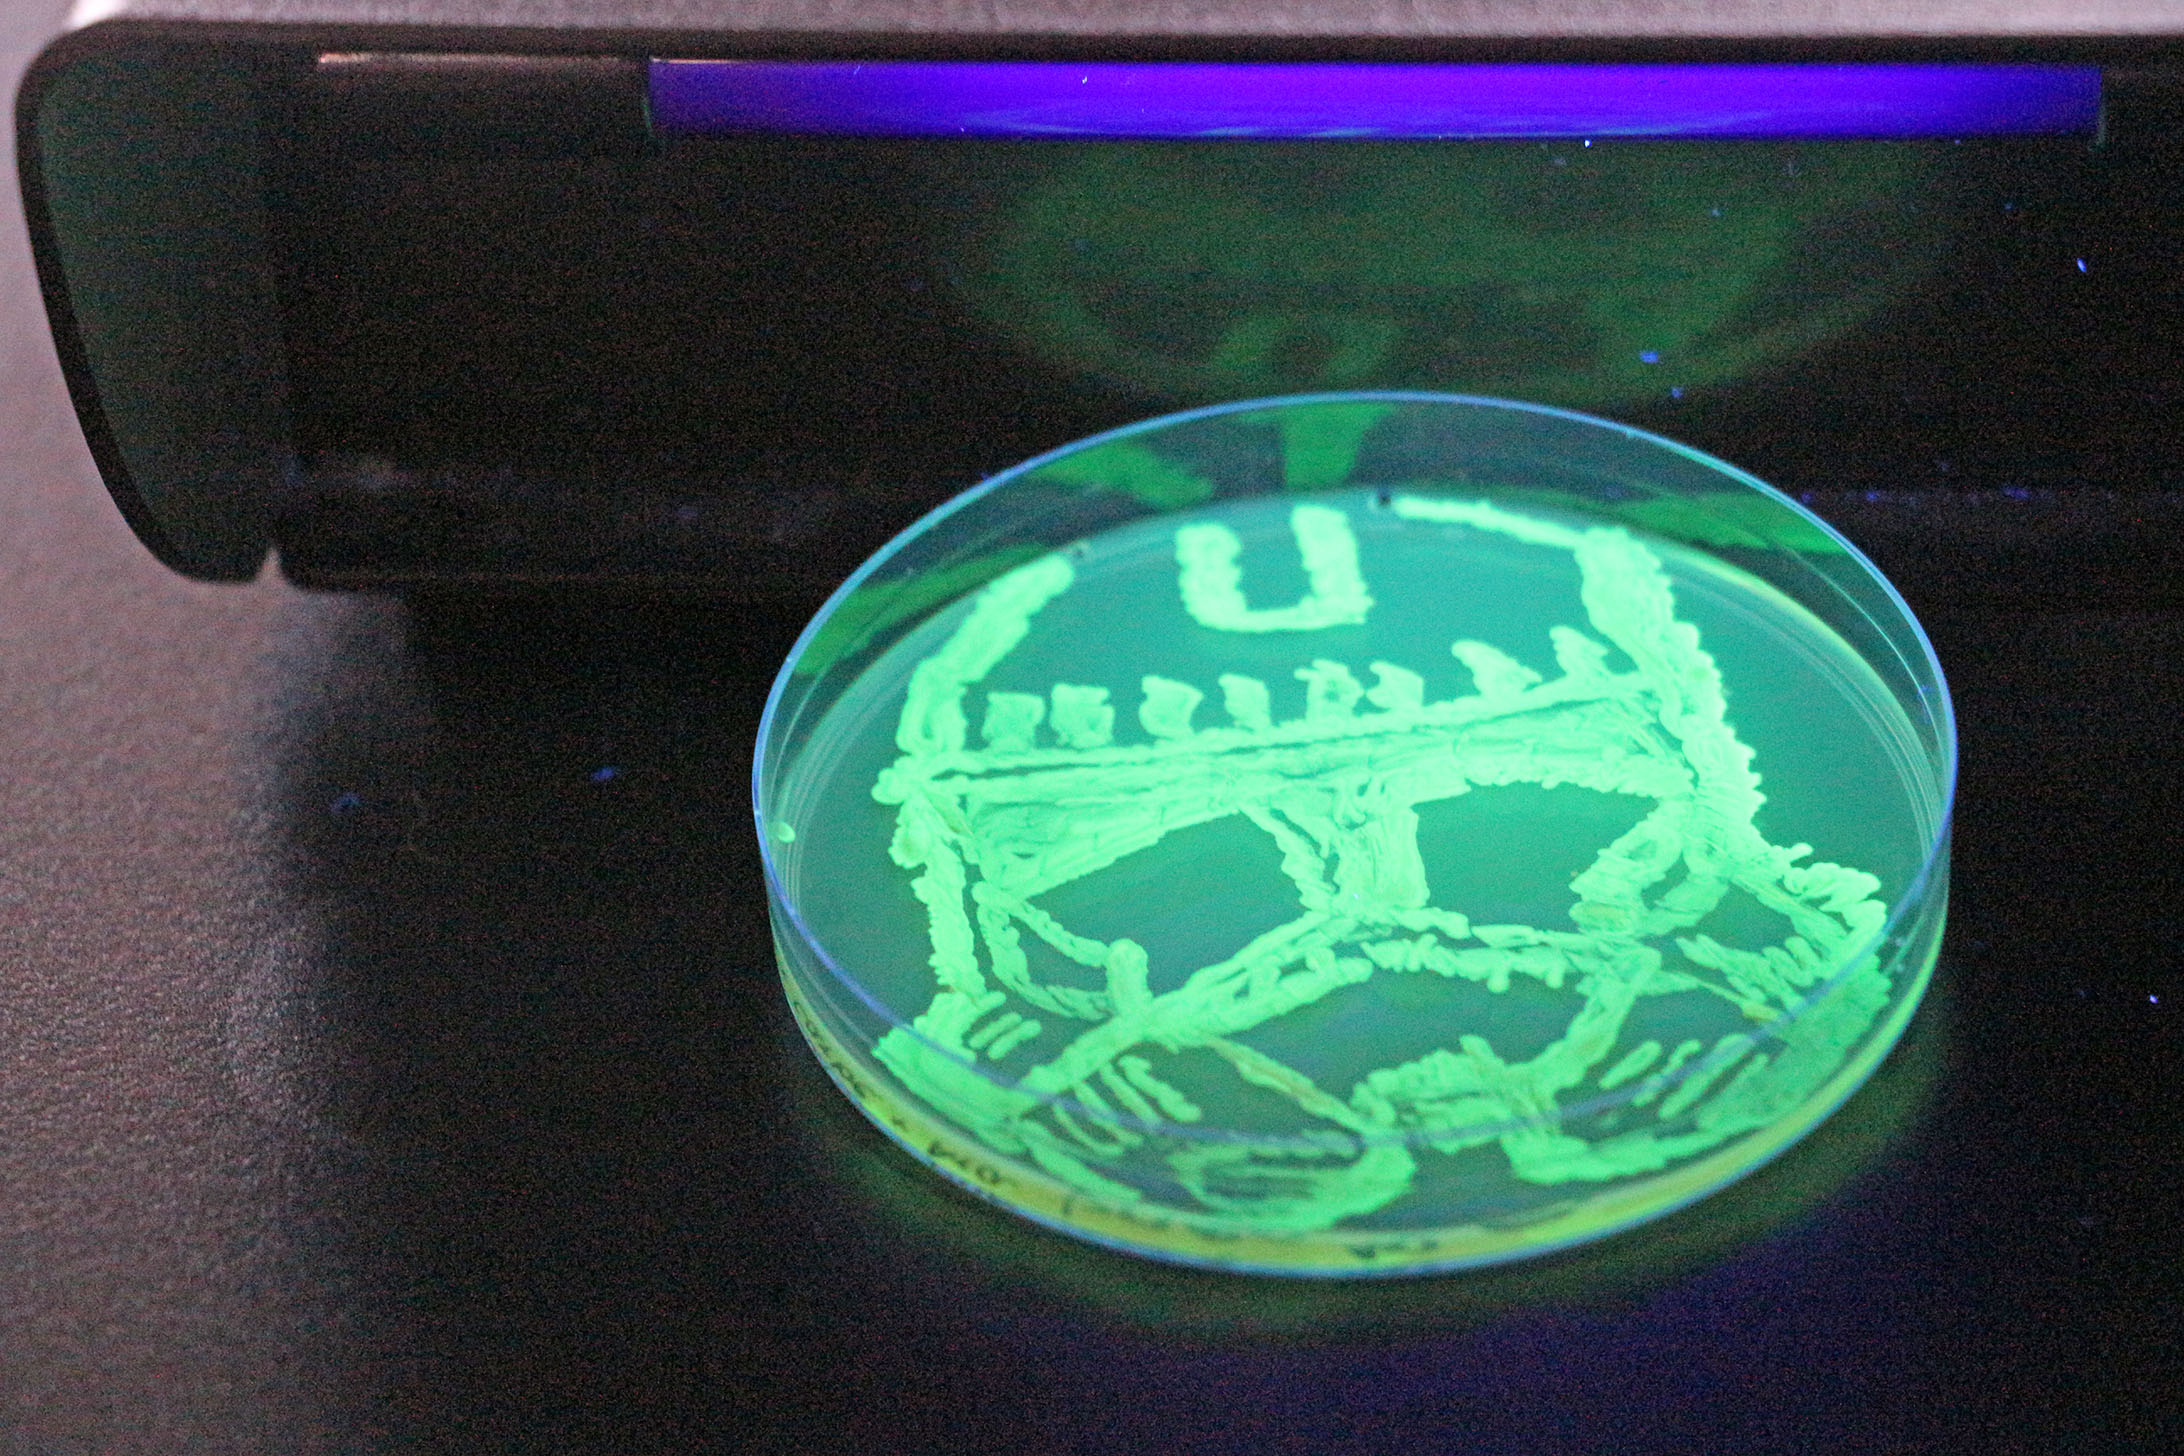

Snoopy y un Stormtrooper brillan en la ciencia: Estudiantes chilenos experimentan y dibujan con proteína fluorescente de medusa
Por CNN Chile
17.11.2025 / 23:21
La iniciativa, que permitió a los alumnos aplicar conceptos de laboratorio mientras exploraban su creatividad, incluyó representaciones de personajes como Snoopy y un Stormtrooper, y se inspira en competencias internacionales de bioarte con aplicaciones reales en biomedicina y biotecnología.
En una iniciativa innovadora, estudiantes del Major de Ingeniería Biológica y Biotecnología de la Universidad Católica (UC) crearon obras de arte a partir de bacterias modificadas genéticamente con la proteína verde fluorescente (GFP), originalmente extraída de la medusa Aequorea victoria.
La actividad, que buscó unir la práctica científica con la creatividad artística, culminó en una exhibición donde los alumnos presentaron dibujos fluorescentes inspirados en personajes animados y de películas, como Snoopy, la Ballerina Capuchina y un Stormtrooper de Star Wars.
“Usamos la proteína verde fluorescente como una forma visible de enseñar la transformación bacteriana y el trabajo en biotecnología. Pero también abrimos espacio para que los estudiantes desarrollen arte con estas bacterias, como si fueran pintura”, explicó el profesor Daniel Garrido, director de Ingeniería Química y Bioprocesos UC.

Cada año, los estudiantes pueden proponer y votar por sus propios diseños, y en esta edición la competencia fue especialmente reñida entre Snoopy y el Stormtrooper por el primer lugar.
Durante el curso, los alumnos aplican conceptos teóricos en el laboratorio utilizando Escherichia coli transformada con un plásmido que permite la expresión de GFP, una proteína ampliamente utilizada en investigación biomédica, bioprocesos y diagnóstico clínico.
El profesor Garrido destacó que esta experiencia se inspira en competencias internacionales de bioarte en laboratorios de biología sintética, donde se utilizan proteínas fluorescentes de distintos colores para generar patrones multicolores.
“Aunque aquí trabajamos con una biomolécula verde, este mismo principio se aplica en proyectos reales como la degradación de plásticos, la producción de insulina, anticuerpos o diagnósticos biomédicos”, puntualizó el académico.